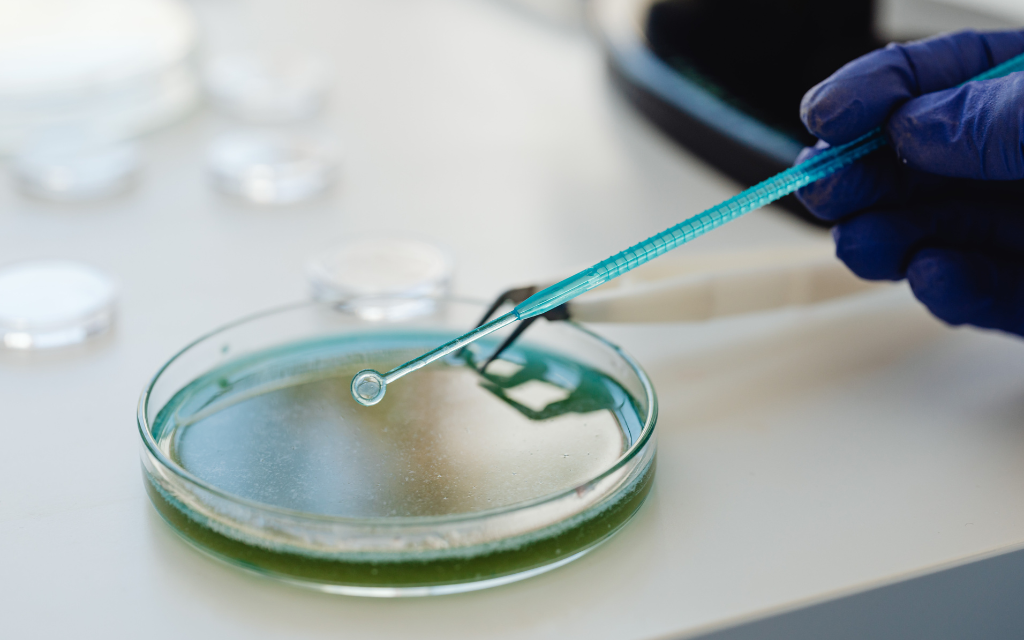

Camminare in casa con le stesse scarpe che usiamo per uscire può sembrare innocuo, ma in realtà porta dentro i nostri ambienti domestici una quantità sorprendente di sporco e batteri. Ogni passo sull’asfalto, sul prato o sulla strada lascia residui di polvere, germi e sostanze chimiche arrivano sulle suole che finiscono sul pavimento di cucina, salotto e camere.
L’abitudine di togliersi le scarpe all’ingresso non è solo una questione di pulizia: crea una barriera efficace contro ciò che si porta da fuori. In questo articolo, approfondiamo le ragioni scientifiche e suggeriamo come introdurre questa pratica in casa, trovando anche il modo più naturale ed educato per chiederla ai nostri ospiti.
Che cosa dicono gli studi
Il problema non riguarda solo foglie o sporco visibile. Mark Patrick Taylor e Gabriel Filippelli, chimici ambientali rispettivamente dell’Environmental Protection Authority dello Stato di Victoria (Australia) e dell’Indiana University (USA), hanno condotto il 360 Dust Analysis Program per analizzare le sostanze presenti nelle abitazioni. Il loro lavoro ha rivelato che scarpe e pavimenti contengono patogeni resistenti agli antibiotici, come Staphylococcus aureus e Clostridium difficile, sostanze chimiche residue dall’asfalto, microplastiche e tossine capaci di interferire con il sistema endocrino.
L’analisi dei campioni provenienti da case in 35 Paesi ha evidenziato anche metalli pesanti come arsenico, cadmio e piombo, e sostanze industriali persistenti come PFAS, che possono avere effetti negativi sulla salute. Alcuni di questi contaminanti sono talmente resistenti da permanere a lungo nell’ambiente domestico, rendendo la pulizia superficiale insufficiente. Questi dati mostrano come togliersi le scarpe prima di entrare possa ridurre significativamente l’introduzione di sostanze pericolose all’interno della propria abitazione, proteggendo chi ci vive, adulti compresi.
Chi rischia di più

Il contatto con il pavimento diventa un rischio soprattutto per chi passa più tempo vicino al suolo. Bambini piccoli che gattonano o mettono le mani in bocca e animali che si leccano possono entrare in contatto diretto con batteri e residui chimici presenti sulle suole. Questi germi possono causare infezioni gastrointestinali, problemi cutanei o altre malattie, in particolare nei soggetti più vulnerabili.
Gli adulti, che trascorrono meno tempo in prossimità del pavimento, hanno meno probabilità di contrarre patologie gravi. La maggior parte dei patogeni diventa pericolosa solo in presenza di ingestione diretta o contatto con feci infette. Restare scalzi riduce comunque la possibilità che queste sostanze si accumulino negli ambienti. Inoltre, la polvere sollevata da una folata di vento o dallo spostamento di oggetti può trasportare germi sugli oggetti domestici e persino sugli alimenti. L’attenzione deve essere massima quando in casa ci sono bambini piccoli, persone immunodepresse o animali domestici che condividono gli spazi abitativi. Questa abitudine riduce l’esposizione a microrganismi nocivi e mantiene le stanze interne della casa più igieniche. Per ridurre polvere e allergeni in casa, dai un’occhiata al nostro articolo sugli acari della polvere e scopri consigli pratici per mantenere gli ambienti più puliti e sicuri.
Come chiedere agli ospiti di togliere le scarpe

Chiedere agli ospiti di levare le scarpe può sembrare un gesto insolito nella cultura occidentale, dove i piedi sono considerati intimi. Nonostante ciò, l’abitudine di rimuovere le calzature è sempre più diffusa, anche in Italia, complice una maggiore attenzione all’igiene domestica dopo gli anni della pandemia.
Vediamo qualche accorgimento per rendere questa pratica meno fastidiosa per chi ci viene a trovare.
- Avvisare in anticipo
Il primo passo è comunicare la regola prima della visita. Gli ospiti possono così indossare calze curate o abbigliamento comodo, evitando situazioni imbarazzanti. Questo permette di rispettare la policy senza creare disagio.
- Creare una seduta dedicata
All’ingresso è utile predisporre una piccola seduta dove gli ospiti possano togliersi le scarpe con facilità. Uno spazio ordinato permette di sistemare le calzature fuori dalla vista, evitando ingombri e facilitando la transizione tra esterno e interno.
- Offrire pantofole di cortesia
Ispirandosi alla tradizione giapponese del Genkan, si possono mettere a disposizione pantofole pulite e lavabili per gli ospiti. Questo gesto semplice aumenta il comfort, rendendo la pratica di levare le calzature naturale e accogliente, senza creare imbarazzo. L’alternativa dei calzascarpe è sicuramente più comoda, ma genera più rifiuti. È importante quindi valutare attentamente questo aspetto.
Spunti per una casa più pulita e sicura
Adottare l’abitudine di rimuovere le scarpe all’ingresso rappresenta un piccolo cambiamento con grande impatto sulla pulizia e sulla salute della casa. Ridurre l’introduzione di batteri, sostanze chimiche e polveri migliora la qualità dell’ambiente domestico e protegge chi vive gli spazi, in particolare bambini e animali. Questo semplice gesto può diventare parte della routine quotidiana e contribuire a un ambiente più sano, igienico e piacevole. Prendersi cura della casa significa anche attenzione ai dettagli quotidiani.
